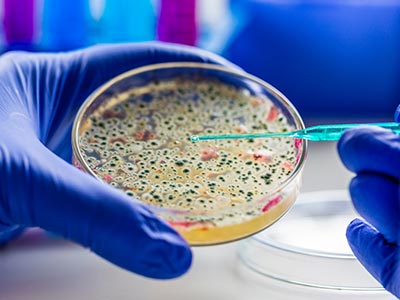

Environmental Services
ELITE MOLD SERVICES has proudly provided our professional services to the Orlando & Central Florida area since 2006
ACAC Certifications
NORMI Certifications
IAC2 Certifications
Over 60+ Years of Combined Experience
Elite Mold Services
Keeping Your Home and Business Environment Safe Since 2006

Elite Mold Services knows that your property is typically your most valuable asset. We treat all our jobs like they were our own. We will have respect for your property and provide honest and reliable recommendations for your best course of action in addressing your mold or indoor air quality issue.


Bacteria and Sewage Contamination Testing
If your home has experienced a sewage backup, flooding, or water damage, it’s crucial to test for bacterial contamination. Harmful bacteria such as E. coli, coliform, and other pathogens can pose serious health risks, especially to children, elderly individuals, and those with weakened immune systems.
At Elite Mold Services, we specialize in bacteria testing and sewage contamination assessments for homes and businesses across Orlando, Winter Garden, Windermere, Tampa and Central Florida. Our professional inspectors use state-of-the-art testing methods to detect harmful bacteria, ensuring your indoor environment is safe and sanitary.
Home Allergen Testing

Indoor air Quality Testing

OSHA IAQ Compliance

One such challenge is receiving an OSHA complaint regarding suspected mold or air quality problems in your workplace. This can be stressful, especially if the complaint is confidential. But don’t panic! Elite Mold Services is here to help you navigate the process efficiently and effectively. We will ensure you stay compliant with addressing the complaint and will help you become aware of any issues that need to be addressed.
Particle Counting
(Particulate Matter)

Post Fire Environmental Testing

At Elite Mold Services, we understand the importance of a safe and healthy environment for you and your family. That’s why we offer comprehensive pre and post fire damage testing for combustion byproducts in Orlando and surrounding areas.
Thermal Imaging Inspections

Thermal imaging is a non-invasive, non-destructive way of evaluating conditions below the surface. Because everything from faulty wiring to the presence of termites to mold to wet insulation affects the surrounding temperature, heat-sensitive photography can reveal these and other issues that just cannot be seen by the naked eye or with conventional or digital photography. We can provide thermal imaging reports where we document the hidden fault for corrective action or to prioritize repairs.
Volatile Organic Compound Testing

“
